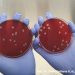
Pakar Kesehatan FK UNS Himbau Masyarakat untuk Mewaspadai Penyakit Antraks – Universitas Sebelas Maret

PURBALINGGA – Bupati Purbalingga Dyah Hayuning Pratiwi mengapreasiasi kontribusi kader Pemberdayaan Kesejateraan Keluarga (PKK) di Kecamatan Kertanegara yang telah ikut serta melakukan pencegahan penularan penyakit Demam Berdarah Dengue (DBD). Ia berharap keterlibatan PKK dalam menyukseskan program pemerintah bisa dilakukan di setiap sektor.
“Saya apresiasi kolaborasi kader PKK dan kader kesehatan dalam melakukan kegiatan Pemberantasan Sarang Nyamuk (PSN). Mudah-mudahkan kegiatan ini bisa rutin dijalankan oleh PKK dan kader kesehatan agar tidak ada lagi kasus DBD di Kertanegara,” kata Bupati Tiwi saat hadir dalam Bimbingan Teknis (Bimtek) Kelembagaan dan Administrasi di Kecamatan Kertanegara, Rabu (12/06/2024).
Tak hanya menekan kasus DBD, Bupati Tiwi berharap kolaborasi kader PKK dan kesehatan bisa terjalin dalam mengentaskan angka stunting yang saat ini masih menjadi pekerjaan rumah (PR) pemerintah. Dijelaskan, saat ini Pemkab Purbalingga mentargetkan penurunan angka stunting bisa turun hingga satu digit di tahun 2024.
“Di PKK ada Pokja 4 (bidang kesehatan) dan Pokja 3 (bidang pangan) yang bisa dilibatkan dalam pengentasan stunting. InsyaAllah dengan banyak kader PKK yang bergerak maka program-program pemerintah bisa berjalan dengan baik,” ujar Bupati Tiwi.
Kepala Puskesmas Karangtengah drg Nursyarifah menjelaskan, berdasarkan data di Puskesmas Karangtengah, persebaran kasus DBD terjadi di Desa Langkap 4 kasus, Desa Karangtengah 1 kasus, Desa Kasih 7 kasus, Desa Kertanegara 4 kasus, Desa Krangean 2 kasus, Desa Krangean 5 kasus, Desa Mergasana 1 kasus, Desa Condong 2 kasus, dan Desa Karangpucung 1 kasus.
“Peningkatan angka kesakitan demam berdarah terjadi di bulan April dan Mei. Dimana pada bulan tersebut puncak musim hujan,” kata dia.
Camat Kertanegara Yunus Wahiddiyantoro mengungkapkan, untuk menekan angka kasus DBD di Kertanegara, kader PKK bekerjasama dengan kader kesehatan melakukan kegiatan Pemberantasan Sarang Nyamuk (PSN) secara rutin setiap pekan.
“PSN dilakukan tiap Jumat dan Minggu pagi. Dan tiap satu bulan sekali tiap Jumat pekan ketiga melakukan PSN serentak semua desa se-Kecamatan Kertanegara,” kata Yunus. (tha/prokompim)